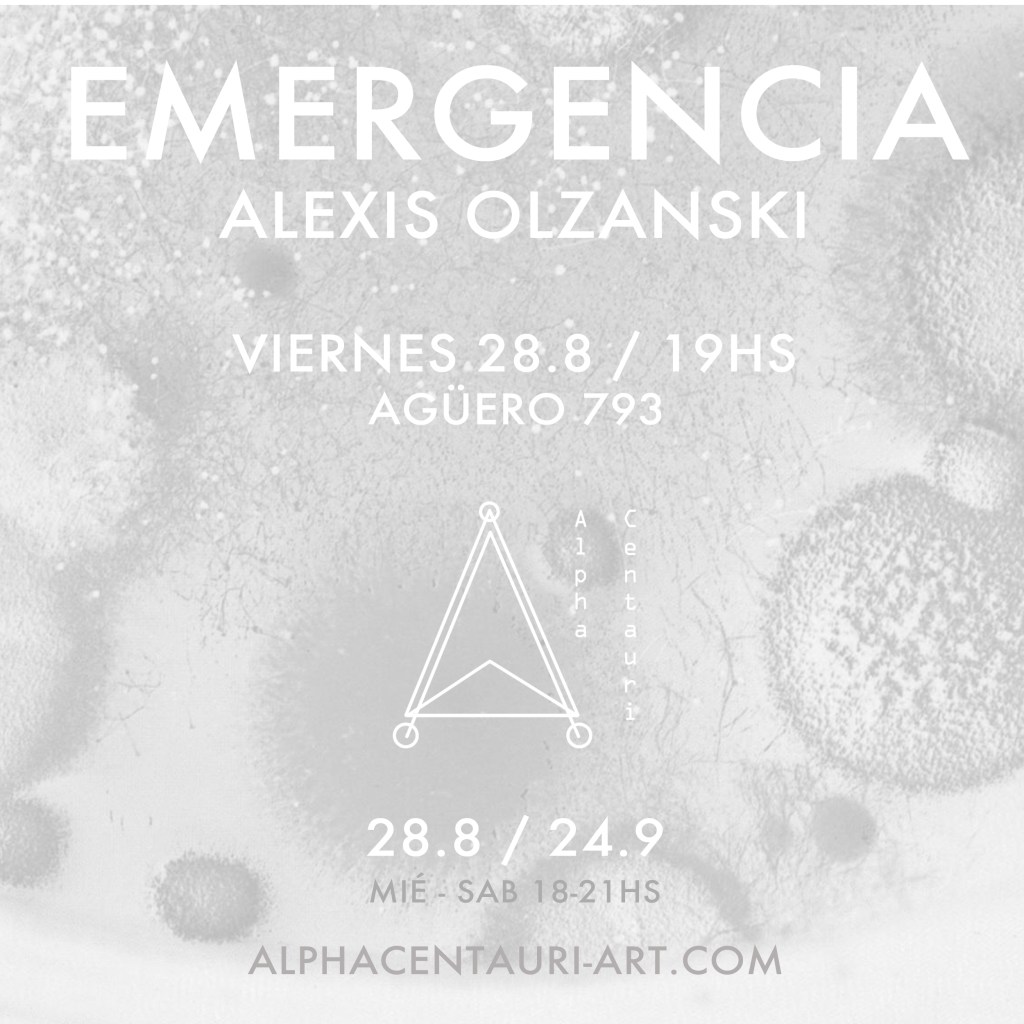

Alpha Centauri fue un espacio de investigación y desarrollo artístico independiente que nació a fines de 2014 como un proyecto personal. Anidado en Espacio Cultural Mi Casa, mantuvo principalmente un formato editorial de galería. Con la particularidad de estar inserto en un ambiente donde funcionaban muchas otras actividades culturales, su carácter era experimental dentro de la práctica artística y curatorial, pero también social.
Durante el 2015 se realizaron once muestras con la participación de artistas nóveles y reconocidos, y de curadores jóvenes, en el que se implementaron gradualmente las ideas iniciales del proyecto: hacer del espacio un centro de práctica y reflexión curatorial; trabajar en pos de la inclusión del arte tecnológico al arte contemporáneo.
En el 2016 el equipo creció y durante ese año fuimos un grupo de cuatro curadores, provenientes de distintas áreas de estudio que nos ocupamos de dirigir la programación y desarrollar actividades en el espacio: Matías Billordo, Enzo Campos Córdoba, Nicolás Frank y Merlina Rañi.
Durante 2017 el espacio funcionó como taller para diferentes artistas, y durante 2018 el espacio volvió a la actividad galerística y experimental bajo la dirección de Nina Kovensky